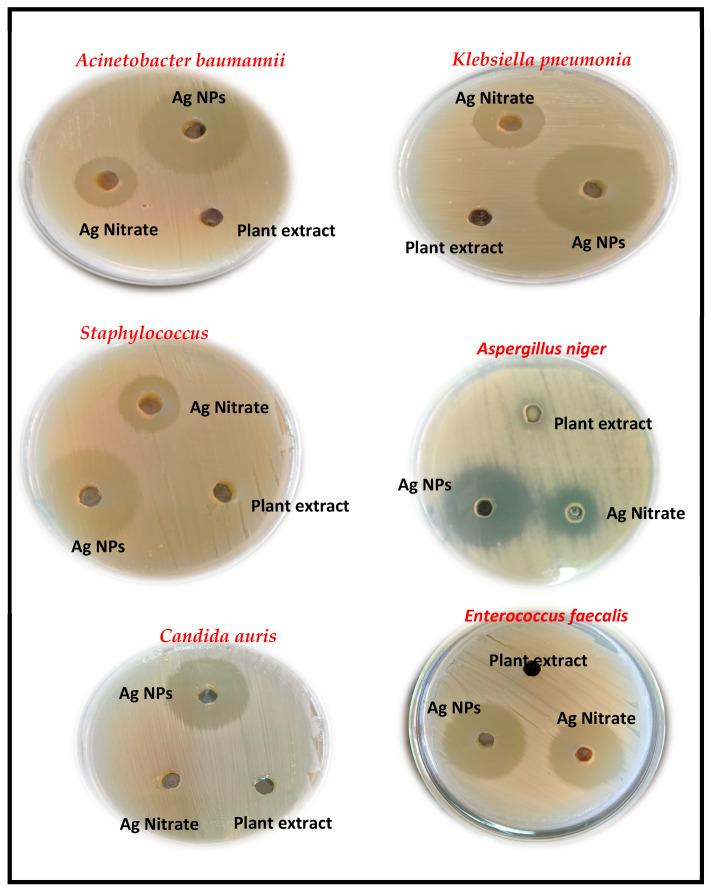
https://cdn.ncbi.nlm.nih.gov/pmc/blobs/04e9/10972527/32dd9ea933c0/medicina-60-00515-g011.jpg

解析生物合成银纳米粒子的抗菌、抗生物膜、抑制()和毒力基因、抗炎和抗氧化潜力。
Unravelling the Antimicrobial, Antibiofilm, Suppressing () and Virulence Genes, Anti-Inflammatory and Antioxidant Potential of Biosynthesized Silver Nanoparticles.
机构信息
Botany and Microbiology Department, Faculty of Science, Al-Azhar University, Nasr City, Cairo 11884, Egypt.
Botany and Microbiology Department, Faculty of Science, Port-Said University, 23 December Street, P.O. Box 42522, Port-Said 42522, Egypt.
出版信息
Medicina (Kaunas). 2024 Mar 21;60(3):515. doi: 10.3390/medicina60030515.
: Urinary tract infections [UTIs] are considered the third most known risk of infection in human health around the world. There is increasing appreciation for the pathogenicity of Gram-positive and Gram-negative strains in UTIs, aside from fungal infection, as they have numerous virulence factors. : In this study, fifty urine samples were collected from patients suffering from UTI. Among the isolates of UTI microbes, six isolates were described as MDR isolates after an antibiotic susceptibility test carried out using ten different antibiotics. An alternative treatment for microbial elimination involved the use of biosynthesized silver nanoparticles (AgNPs) derived from []. : The sizes and shapes of AgNPs were characterized through TEM imaging, which showed spherical particles in a size range of 35-80 nm, of which the average size was 53 nm. Additionally, the silver nanoparticles (AgNPs) demonstrated inhibitory activity against (OR648079), exhibiting a 31 mm zone of inhibition at a minimum inhibitory concentration (MIC) of 4 mg/mL and a minimum bactericidal concentration (MBC) of 8 mg/mL. This was followed by (OR648075), which showed a 30 mm inhibition zone at an MIC of 16 mg/mL and a minimum fungicidal concentration (MFC) of 32 mg/mL. Then, (OR648078), (OR648081), and (OR648080) each displayed a 29 mm zone of inhibition at an MIC of 8 mg/mL and an MBC of 16 mg/mL. The least inhibition was observed against (OR648076), with a 25 mm inhibition zone at an MIC of 16 mg/mL and an MFC of 32 mg/mL. Furthermore, AgNPs at different concentrations removed DPPH and HO at an IC50 value of 13.54 μg/mL. Also, AgNPs at 3 mg/mL showed remarkable DNA fragmentation in all bacterial strains except . The phytochemical analysis showed the presence of different active organic components in the plant extract, which concluded that rutin was 88.3 mg/g, garlic acid was 70.4 mg/g, and tannic acid was 23.7 mg/g. Finally, AgNPs concentrations in the range of 3-6 mg/mL showed decreased expression of two of the fundamental genes necessary for biofilm formation within , (6 folds), and (12.5 folds) when compared with the gene, which decreased by one-fold when compared with the control sample. These two genes were submitted with NCBI accession numbers [OR682119] and [OR682118], respectively. : The findings from this study indicate that biosynthesized AgNPs from exhibit promising antimicrobial and antioxidant properties against UTI pathogens, including strains resistant to multiple antibiotics. This suggests their potential as an effective alternative treatment for UTIs. Further research is warranted to fully understand the mechanisms of action and to explore the therapeutic applications of these nanoparticles in combating UTIs.
尿路感染[UTIs]被认为是全球人类健康中第三大已知感染风险。除了真菌感染之外,人们越来越意识到革兰氏阳性和革兰氏阴性菌株在 UTIs 中的致病性,因为它们具有许多毒力因子。在这项研究中,从患有 UTI 的患者中收集了 50 份尿液样本。在 UTI 微生物的分离物中,经过十种不同抗生素的抗生素药敏试验后,有六种分离物被描述为 MDR 分离物。微生物消除的替代治疗方法涉及使用生物合成的银纳米粒子(AgNPs),这些 AgNPs 来自[ ]。AgNPs 的大小和形状通过 TEM 成像进行了表征,结果显示出球形颗粒,粒径范围为 35-80nm,平均粒径为 53nm。此外,银纳米粒子(AgNPs)对[ ](OR648079)表现出抑制活性,在最低抑菌浓度(MIC)为 4mg/mL 和最低杀菌浓度(MBC)为 8mg/mL 时表现出 31mm 的抑菌区。其次是[ ](OR648075),在 MIC 为 16mg/mL 和最低真菌杀菌浓度(MFC)为 32mg/mL 时表现出 30mm 的抑制区。然后,[ ](OR648078)、[ ](OR648081)和[ ](OR648080)在 MIC 为 8mg/mL 和 MBC 为 16mg/mL 时分别显示出 29mm 的抑菌区。对[ ](OR648076)的抑制作用最小,在 MIC 为 16mg/mL 和 MFC 为 32mg/mL 时抑制区为 25mm。此外,AgNPs 在不同浓度下以 13.54μg/mL 的 IC50 值去除 DPPH 和 HO。此外,AgNPs 在 3mg/mL 时除[ ]外,所有细菌菌株均表现出明显的 DNA 片段化。植物提取物的植物化学分析表明存在不同的活性有机成分,其中芦丁含量为 88.3mg/g,大蒜酸含量为 70.4mg/g,单宁酸含量为 23.7mg/g。最后,AgNPs 浓度在 3-6mg/mL 范围内时,与对照样品相比,[ ](6 倍)和[ ](12.5 倍)中两个必需基因的表达水平降低,而[ ]基因降低了一倍。这两个基因已提交给 NCBI 注册号[OR682119]和[OR682118]。这项研究的结果表明,从[ ]生物合成的 AgNPs 对尿路感染病原体具有有前途的抗菌和抗氧化特性,包括对多种抗生素耐药的菌株。这表明它们有潜力成为治疗尿路感染的有效替代方法。需要进一步研究以充分了解其作用机制,并探索这些纳米粒子在治疗尿路感染中的治疗应用。